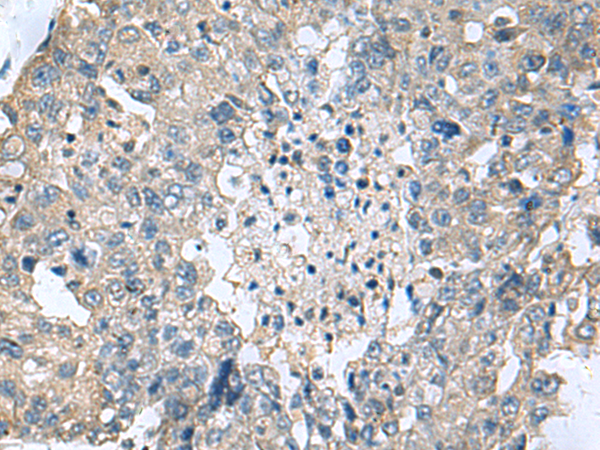
一抗

|
Background: |
Transglutaminases are enzymes that catalyze the crosslinking of proteins by epsilon-gamma glutamyl lysine isopeptide bonds. While the primary structure of transglutaminases is not conserved, they all have the same amino acid sequence at their active sites and their activity is calcium-dependent. The protein encoded by this gene consists of two polypeptide chains activated from a single precursor protein by proteolysis. The encoded protein is involved the later stages of cell envelope formation in the epidermis and hair follicle. |
|
Applications: |
ELISA, WB, IHC |
|
Name of antibody: |
TGM3 |
|
Immunogen: |
Fusion protein of human TGM3 |
|
Full name: |
transglutaminase 3 |
|
Synonyms: |
TGE; UHS2 |
|
SwissProt: |
Q08188 |
|
ELISA Recommended dilution: |
5000-10000 |
|
IHC positive control: |
Human liver cancer |
|
IHC Recommend dilution: |
50- 200 |
|
WB Predicted band size: |
77 kDa |
|
WB Positive control: |
Human tongue tissue lysate |
|
WB Recommended dilution: |
1000-5000 |


 購物車
購物車 幫助
幫助
 021-54845833/15800441009
021-54845833/15800441009